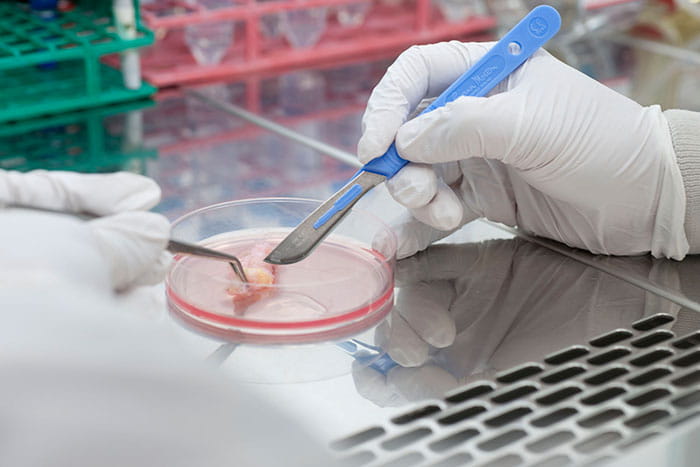

PGCert: Launchpad
Enhance your surgical career
The PGCert in Surgery is a unique online programme that allows you to study at your own pace over 1-2 years.
The PGCert is a nationally recognised qualification that will enhance your surgical career in many ways. It gives you the opportunity to:
- Develop and demonstrate your systematic knowledge in a range of self-selected disciplines
- Gain skills in decision making, problem solving and the management of complex issues
- Improve your skills in self-direction and autonomous learning
- Gain an RCS England certificate to support your career development
- Prove your dedication to a career in surgery
You can take standalone modules or enrol on the whole programme for extra benefits!
Already enrolled?

About the PGCert in Surgery
The PGCert in Surgery is a flexible and interactive way to build up invaluable surgical knowledge and skills.
Designed to complement your workplace learning, the modules focus on different aspects of clinical surgery across the specialties.
The PGCert in Surgery is a nationally recognised qualification with all modules developed by experienced surgeons across the specialties. It will support you in preparing for national specialty selection, offering an ideal way to develop your skills, while demonstrating your commitment to surgery.
The qualification is mapped to the ISCP syllabus and also aligned to level 7 (postgraduate level) of the QAA’s Framework for Higher Education.
For learning outcomes, see individual modules.
The PGCert Surgery is delivered in English.
Suitability
The PGCert in Surgery is designed for FY1-2, CT1-2 and members of the surgical care team. It is particularly suitable if you are preparing to take the MRCS exam, and will enhance any application for specialty selection.
To be eligible, you must have successfully completed an undergraduate degree in a healthcare-related subject and have access to an appropriate supervisor with whom you can discuss your progress.
You can also take any of the modules as a standalone course at any stage of your career.
Some modules require the submission of Workplace Based Assessments (WBAs). Information regarding the WBAs required can be found on the individual module page, in the ‘Format’ tab. Please ensure you have a suitable supervisor who can undertake your assessment.
For more information on WBAs, please consult the ISCP website. If you do not have an Assigned Educational Supervisor, you can use the ISCP guidance to find a suitable alternative, for example, within the Case Based Discussion guidance.
Fees
If you enrol on the full PGCert, you pay a programme enrolment fee. You then buy individual modules of your choice, at a discounted rate. If you don’t want to join the full PGCert, you can buy individual modules as a standalone product.
Programme enrolment fee
The PGCert Programme fee includes:
- Launchpad module
- Exclusive RCS anatomy videos
- 6 SURGERY eBooks published by Elsevier
- 1 year's free membership of the RCS Affiliate scheme (terms and conditions apply)
All other online modules have additional fees.
Standard Programme fee: £420
Programme fee for RCS members (10% discount): £378
Programme extension fee
£150 for an additional 6 months enrolment.
Online module fees
Module fees give you access to each module for 6 months. Fees vary depending on whether or not you are already enrolled in the full PGCert programme.
Standard standalone module fee:
- 3 credit module = £220
- 6 credit module = £320
- 10 credit module = £420
Standalone module fee for RCS members (10% discount):
- 3 credit module = £198
- 6 credit module = £288
- 10 credit module = £378
Module fee if enrolled on PGCert in Surgery (15% discount):
- 3 credit module = £187
- 6 credit module = £272
- 10 credit module = £357
Only the higher discount applies: discounts cannot be combined.
Module extension fee
From £65 per module for an additional 6 months.
Enrol on the PGCert in Surgery
Please ensure you are logged in to your account or, if you do not have an account, have registered.
How it works
View a short You Tube video on the PGCert.
You will complete a series of interactive online modules and assessments through the RCS England e-learning platform, choosing modules to suit your career path.
Each one earns you credits: you need 60 credits to achieve the PGCert in Surgery qualification.
As well as taking online modules, you can gain up to 20 credits from taking selected RCS England practical courses (range and dates subject to availability). Courses you have already taken count towards your credit total.
View PGCert in Surgery associated courses
'Launchpad' module
You can gain an additional 6 credits by answering at least two of the six series of multiple choice questions (MCQs) based on the SURGERY eBooks that are sent to you on enrolment.
Time limit
Once enrolled, you will have up to 2 years to accrue the 60 credits needed to complete the PGCert in Surgery. If you need to, you can extend your PGCert in Surgery access for £150.
Your personalised PGCert in Surgery dashboard will show you when access to each module is due to end, how much you’ve completed of each module and how many credits you have accrued.
You have access to each module for six months from the date of purchase. We advise that you purchase each module when you intend to start it, to ensure you can complete it within the time limit.
Technical requirements
Please see our Minimum Technical Requirements for e-learning.
Full programme or standalone modules
The full PGCert in Surgery requires 60 credits, but if doing the full programme doesn’t suit you right now, you can also take individual modules on a standalone basis.
If you decide to enrol on the full programme later, modules you have already taken count towards the 60 credit total.
Both ways of studying have the same core benefits:
- Choose online modules to complement your personal career path
- Access each of your modules for 6 months, working through them at your own speed
- Study via the innovative RCS e-learning platform – using any device, whenever and wherever it suits you
If you enrol on the full PGCert programme, you’ll also benefit from:
- Personalised PGCert in Surgery dashboard
- 15% discount on module prices
- Exclusive RCS anatomy videos
- 6 SURGERY eBooks published by Elsevier
- 1 year's free membership of the RCS England Affiliate scheme (terms and conditions apply)
If you are planning to complete the full PGCert in Surgery, we recommend that you plan to purchase and complete the modules across the permitted 2 years. You can choose the speed at which you wish to complete modules, but once purchased, you must complete individual modules within 6 months.
Cancellation Policy
The general RCS Education Terms and Conditions are applicable to the PGCert in Surgery.
Specifically, section 2.5 states that if you wish to cancel your place on an e-learning programme or online module (i.e. courses delivered and assessed online) you must notify us by email within 24 hours of booking.
Unfortunately, refunds cannot be processed for cancellation requests placed after this time period.

Modules

PGCert: Breast Surgery

PGCert: Consent and Ethics

PGCert: Energy in Surgery - part 1

PGCert: Energy in Surgery - part 2

PGCert: Minimally Invasive Surgery

PGCert: Orthopaedics

PGCert: Day Surgery

PGCert: Hernia
PGCert: Introduction to plastic surgery

PGCert: Paediatric Surgical Emergencies

PGCert: Proctology

PGCert: Urology

PGCert: Postoperative Care

PGCert: Preoperative Care

PGCert: Research Methodologies
Contact the education team
If you have any questions about the PGCert in Surgery, or any other RCS courses, please get in touch.
The RCS Education Centre in London can be contacted directly on education@rcseng.ac.uk
We will endeavour to reply to you as soon as possible. Usually this is within a couple of days. Please note we do not work weekends.
Phone us
Call 020 7869 6300 to talk with a member of our team.
We are available to answer calls during our working hours of 8:30am - 4:30pm, Monday - Friday and there is a voicemail outside this time.